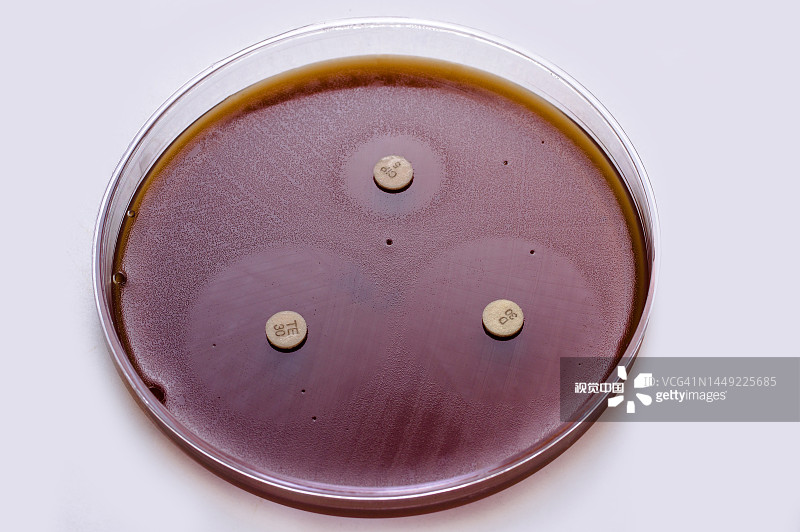

淋病也就是通常说的淋球菌感染,主要是革兰阴性菌的细菌感染,从道理上来说,可能会引起发烧这种临床表现。但实际上淋球菌的感染有一个特点,主要侵犯的是尿道,基本上不会进入到血,局部的这种一个感染灶,极少会引起全身的症状,全身不适的这种表现。主要临床表现就是大量的脓性分泌物,还有尿道口的这种红肿,真正引起发烧的非常少。
如果是真的出现发烧了,也没关系,通过抗生素的治疗,这种症状包括局部的症状,都会有显著的一个改善。但是如果同时有高热,是不是要考虑到有没有其他的合并感染的问题?因此如果真是出现发烧了,还是要请医生帮你看一下,看看除了淋球菌的感染以外,有没有其他的问题,有没有全身的其他一些病灶同时存在。
单纯的尿路感染,淋球菌的尿道炎,基本上不会出现发热的一种表现的。因此出现发热这种表现的时候,还是要请医生判断一下。
来源:杏林普康






